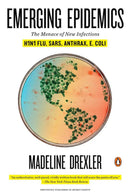
Emerging Epidemics-Family and health-買書書 BuyBookBook

Description
By: Madeline Drexler
As timely as it is urgent, the well-researched book from veteran science journalist Madeline Drexler delivers a compelling report about today's most ominous infections disease threats. Focusing on a different danger in each chapter-from the looming risk of lethal influenza to in-depth information on the public health perils posed by bioterrorism-Drexler takes readers straight to the front lines, where scientists are racing to catch nearly invisible adversaries superior in speed and guile. Drawing on a powerful combination of fresh research and surprising history, she warns us that the most ceaselessly creative bioterrorist is still Mother Nature, whose microbial operatives are all around us, ready to ounce whenever conditions are right.
As timely as it is urgent, the well-researched book from veteran science journalist Madeline Drexler delivers a compelling report about today's most ominous infections disease threats. Focusing on a different danger in each chapter-from the looming risk of lethal influenza to in-depth information on the public health perils posed by bioterrorism-Drexler takes readers straight to the front lines, where scientists are racing to catch nearly invisible adversaries superior in speed and guile. Drawing on a powerful combination of fresh research and surprising history, she warns us that the most ceaselessly creative bioterrorist is still Mother Nature, whose microbial operatives are all around us, ready to ounce whenever conditions are right.
You may also like
Top Trending

Dog Man 14: Dog Man: Big Jim Believes: A Graphic Novel (Dog Man #14)
Sale priceHK$85.00
Regular priceHK$150.00
In stock
Press Start! #17 The Super Jump Between Worlds! (Branches)
Sale priceHK$55.00
Regular priceHK$98.00
In stock
Anzu and the Realm of Darkness: A Graphic Novel
Sale priceFrom HK$85.00
Regular priceHK$140.00
In stock
The Midnight Heist (Geronimo Stilton and The Kingdom of Fantasy #17)
Sale priceHK$128.00
Regular priceHK$200.00
In stock
Cat Kid Comic Club (正版) #04 Collaborations (Dav Pilkey)
Sale priceFrom HK$65.00
Regular priceHK$90.00
In stock